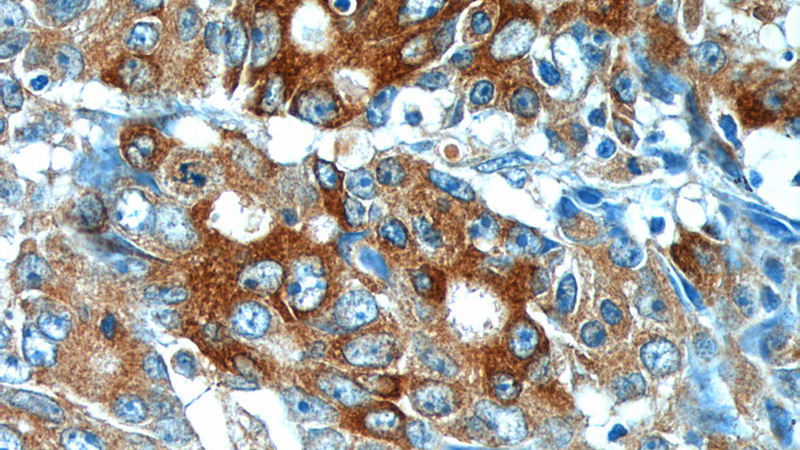

-
Product Name
IL-17 antibody
- Documents
-
Description
IL-17 Rabbit Polyclonal antibody. Positive IHC detected in human colon cancer tissue, human prostate cancer tissue. Positive WB detected in U-937 cells, human testis tissue, mouse thymus tissue, mouse uterus tissue, Transfected HEK-293 cells. Positive IP detected in U-937 cells. Observed molecular weight by Western-blot: 32-35 kDa
-
Tested applications
ELISA, IP, WB, IHC
-
Species reactivity
Human, Mouse; other species not tested.
-
Alternative names
CTLA 8 antibody; CTLA8 antibody; IL 17 antibody; IL 17A antibody; IL17 antibody; IL-17 antibody; IL17A antibody; interleukin 17A antibody
-
Isotype
Rabbit IgG
-
Preparation
This antibody was obtained by immunization of IL-17 recombinant protein (Accession Number: NM_002190). Purification method: Antigen affinity purified.
-
Clonality
Polyclonal
-
Formulation
PBS with 0.02% sodium azide and 50% glycerol pH 7.3.
-
Storage instructions
Store at -20℃. DO NOT ALIQUOT
-
Applications
Recommended Dilution:
WB: 1:200-1:2000
IP: 1:200-1:1000
IHC: 1:50-1:500
-
Validations

U-937 cells were subjected to SDS PAGE followed by western blot with Catalog No:111762(IL17A antibody) at dilution of 1:500

Immunohistochemistry of paraffin-embedded human colon cancer tissue slide using Catalog No:111762(IL17A Antibody) at dilution of 1:200 (under 10x lens).
Immunohistochemistry of paraffin-embedded human colon cancer tissue slide using Catalog No:111762(IL17A Antibody) at dilution of 1:200 (under 40x lens).

Transfected HEK-293 cells were subjected to SDS PAGE followed by western blot with Catalog No:111762(IL17A Antibody) at dilution of 1:500

IP Result of anti-IL17A (IP:Catalog No:111762, 3ug; Detection:Catalog No:111762 1:300) with U-937 cells lysate 6500ug.
-
Background
IL17A, also named as IL-17, is a proinflammatory cytokine. IL-17, synthesized only by memory T cells and natural killer cells, has pleiotropic effects, mainly in the recruitment and activation of neutrophils. This cytokine regulates the activities of NF-kappaB and mitogen-activated protein kinases. This cytokine can stimulate the expression of IL6 and cyclooxygenase-2 (PTGS2/COX-2), as well as enhance the production of nitric oxide (NO). High levels of this cytokine are associated with several chronic inflammatory diseases including rheumatoid arthritis, psoriasis and multiple sclerosis. The IL-17 receptor is a type I transmembrane protein, that is widely expressed on epithelial cells, fibroblasts, B and T cells, and monocytic cells. In psoriatic skin lesions, both Th17 cells and their downstream effector molecules, e.g. IL-17 and IL-22, are highly increased. This antibody got 32-35 kDa band in western blot, maybe due to homodimer formation and differential glycosylations.
-
References
- Xie S, Ding L, Xiong Z, Zhu S. Implications of Th1 and Th17 cells in pathogenesis of oral lichen planus. Journal of Huazhong University of Science and Technology. Medical sciences = Hua zhong ke ji da xue xue bao. Yi xue Ying De wen ban = Huazhong keji daxue xuebao. Yixue Yingdewen ban. 32(3):451-7. 2012.
- Rodero MP, Hodgson SS, Hollier B, Combadiere C, Khosrotehrani K. Reduced Il17a expression distinguishes a Ly6c(lo)MHCII(hi) macrophage population promoting wound healing. The Journal of investigative dermatology. 133(3):783-92. 2013.
- Li Q, Li Q, Chen J. Prevalence of Th17 and Treg cells in gastric cancer patients and its correlation with clinical parameters. Oncology reports. 30(3):1215-22. 2013.
- Ardeljan D, Wang Y, Park S. Interleukin-17 retinotoxicity is prevented by gene transfer of a soluble interleukin-17 receptor acting as a cytokine blocker: implications for age-related macular degeneration. PloS one. 9(4):e95900. 2014.
- Gong Y, Li H, Li Y. Effects of Bacillus subtilis on Epithelial Tight Junctions of Mice with Inflammatory Bowel Disease. Journal of interferon & cytokine research : the official journal of the International Society for Interferon and Cytokine Research. 36(2):75-85. 2016.
Related Products / Services
Please note: All products are "FOR RESEARCH USE ONLY AND ARE NOT INTENDED FOR DIAGNOSTIC OR THERAPEUTIC USE"
